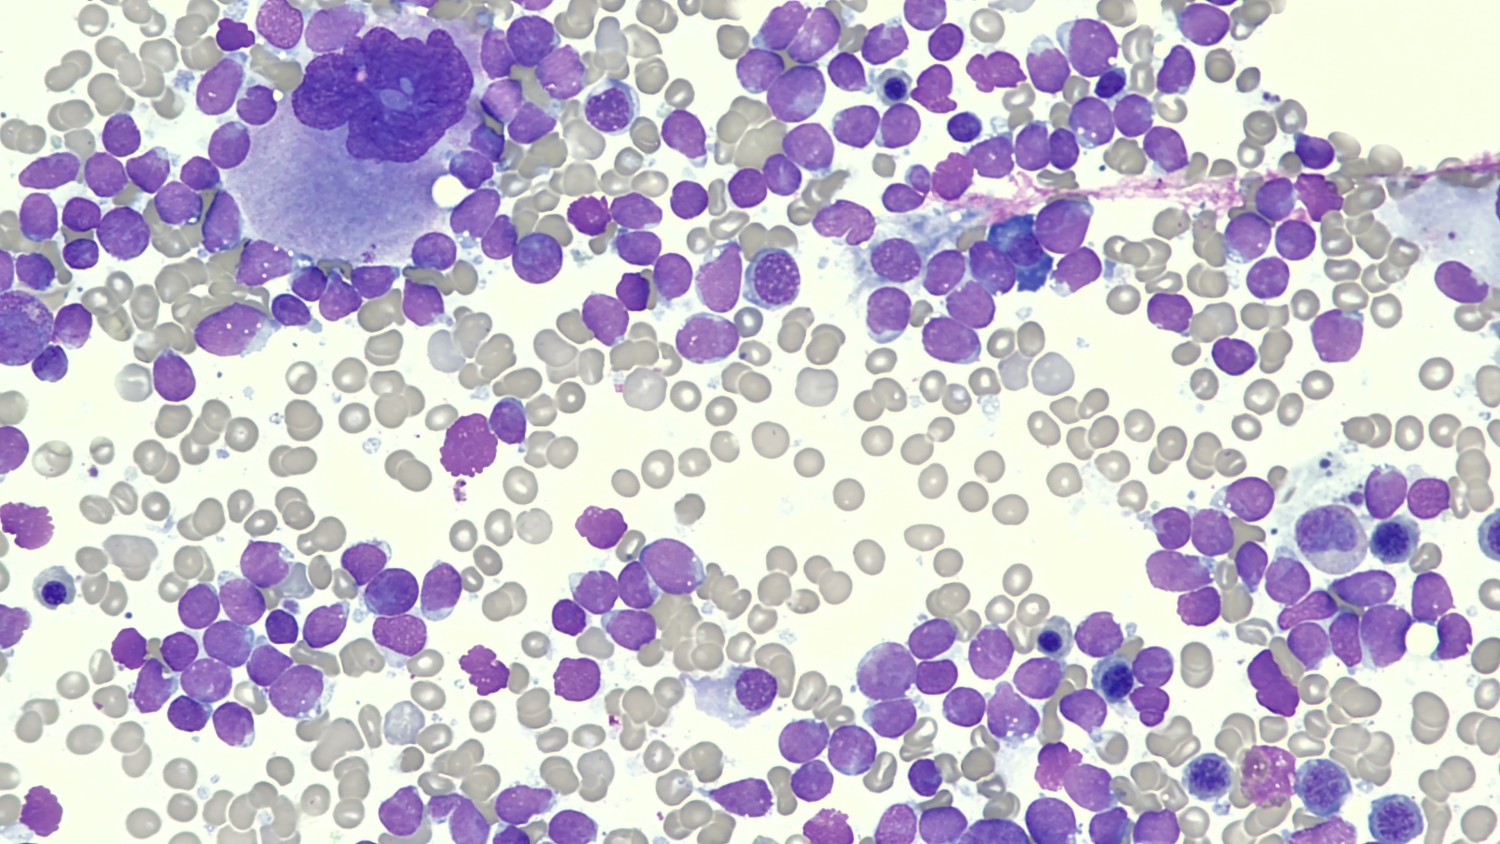
Figur 1 Beinmergsutstryk 400&times; forst&oslash;rring. Beinmergen er dominert av mellomstore, monotone celler med liten cytoplasma:&hellip;

Blodprøveavvik er ei vanleg problemstilling i primær- og spesialisthelsetenesta. Årsaka er ofte multifaktoriell, og utgreiing skjer gjerne på tvers av ulike spesialitetar. Vi presenterer her historia til ein pasient med tilfeldig påviste forstyrringar i blodbildet, med ein uventa og alvorleg årsakssamanheng.
Ein ung mann med Aspergers syndrom oppsøkte legevakt grunna kroppsleg og mental uro. Pasienten hadde frå før kjent epilepsi, og eit par dagar i forvegen hadde han hatt ei rekke epileptiske anfall etter inntak av alkohol. På legevakta forklarte han at tunga og pusten hans hadde hengt seg opp og at alle luftrøyra i kroppen hadde tømt seg for luft. Han meinte nå at luftrøyra var i ferd med å fylle seg opp igjen, moglegvis med spytt.
Pasienten hadde hatt liknande episodar med vrangførestillingar tidlegare. Dei siste fem månadane hadde han derfor brukt peroral olanzapin 2,5 mg × 1 som førebyggande behandling. Han brukte i tillegg peroral okskarbazepin 1 800 mg × 2 mot epilepsi. Ved alle dei tidlegare psykotiske episodane hadde pasienten drukke alkohol få dagar i forvegen, og ved ein av episodane hadde han hatt epileptiske anfall to dagar før han blei lagt inn. Dei psykotiske symptoma forsvann i løpet av ein til tre dagar i alle tilfella.
På legevakta var pasienten afebril, hadde blodtrykk på 122/88 mmHg og puls på 89 per minutt. Funna ved klinisk undersøkelse var normale. Blodprøvene viste alvorleg nøytropeni, leukopeni og lett trombocytopeni og anemi, med nøytrofiltal på 0,24 × 109/L (referanseområde 1,80–6,90 × 109/L) leukocyttal på 1,3 × 109/L (4,10–9,80 × 109/L), hemoglobinnivå på 11,7 g/dL (13,7–17,0) og trombocyttal på 131 × 109/L (164–370 × 109/L). CRP var på 28 mg/L. Pasienten blei frivillig lagt inn på psykiatrisk akuttavdeling med mistanke om psykose.
Aspergers syndrom og epilepsi er assosiert med psykose. Det er haldepunkt i litteraturen for auka førekomst av positive psykotiske symptom hos pasientar med autismespekterlidingar (1). Epilepsipasientar har nesten åtte gongar auka risiko for psykose samanlikna med personar utan epilepsi (2). Dette var fjerde gongen pasienten blei lagt inn på psykiatrisk avdeling grunna akutt oppståtte somatiske vrangførestillingar.
Dagen etter innkomst i psykiatrisk akuttavdeling hadde pasienten framleis vrangførestillingar. Peroral olanzapin blei auka til 5 mg × 2, og vrangførestillingane avtok over dei neste dagane. Ved overflytting til lokalt distriktspsykiatrisk senter fem dagar seinare var vrangførestillingane tydeleg dempa. Det blei ikkje observert vidare teikn til vrangførestillingar etter overflytting. Behandlingsfokuset blei heretter retta mot blodprøveavvika.
Blodprøver tatt dagen etter overflytting til lokalt distriktspsykiatrisk senter bekrefta leukopeni med alvorleg nøytropeni. Journaloppslag viste signifikant fall i alle tre cellelinjene frå fem månadar tidlegare, med fall i hemoglobinnivå frå 15,1 g/dL til 11,2 g/dL (13,7–17,0), trombocyttal frå 284 × 109/L til 129 × 109/L (164–370 × 109/L) og nøytrofile granulocyttal frå 0,97 × 109/L til 0,13 × 109/L (1,80–6,90 × 109/L). Gjennomsnittleg cellevolum i dei raude blodcellene (MCV) var 90 fL (81–95), CRP 8 mg/L (< 5), aktivt vitamin B12 var 237 pmol/L (170–660) og ferritin 798 µg/L (23–431). Klinisk undersøkelse viste normale funn. Det blei ikkje sett petekkiar, og pasienten nekta for blødings- og infeksjonstendens, vekttap, feber eller nyoppstått nattesveitte.
Blodprøveavvika blei diskutert med hematolog. Biverknad av okskarbazepin og olanzapin blei peikt på som moglege årsaker. Pasienten hadde brukt okskarbazepin i fleire år og hadde normale funn på blodprøver hos nevrolog ti månadar før det aktuelle, noko som svekte mistanken rundt dette legemiddelet. Pasienten blei på dette tidspunktet ikkje lenger vurdert å vere psykotisk, og olanzapin blei seponert i forsøk på å korrigere blodbildet. Nivået av aktivt vitamin B12 var i nedre normalområde, og det blei starta regime med daglege vitamin B12-injeksjonar for å korrigere eventuell B12-mangel.
Fleire antipsykotiske medikament kan gi nøytropeni. Eit godt døme i denne samanhengen er klozapin. Bruken av klozapin er som regel avgrensa til behandlingsresistente tilfelle av schizofreni, grunna fleire alvorlege biverknadar. Risikoen for å utvikle alvorleg nøytropeni eller agranulocytose er rundt 1 % (3). Olanzapin er strukturelt i slekt med klozapin og dannar metabolittar som er toksiske for granulocyttar (3). Felleskatalogen oppgir at olanzapin, i likskap med klozapin, kan gi både nøytropeni og trombocytopeni (4). I vårt tilfelle hadde pasienten brukt olanzapin fast i fem månadar, med klar biokjemisk reduksjon i alle dei hematologiske cellelinjene etter oppstart. Sjølv om det ikkje blei sett klar samanheng mellom anemien og antipsykotisk behandling, blei medikamentet seponert som ledd i utgreiinga.
Vitamin B12 (kobalamin) inngår i ei rekke livsviktige cellemetabolske prosessar. Celler som deler seg hyppig, har stort forbruk av kobalamin. Mangeltilstandar går derfor hardt ut over beinmergen. Defekt hematopoese gir anemi, trombocytopeni og granulocytopeni. Kroppen er utelukkande avhengig av ekstern tilførsel av kobalamin, og det daglege anbefalte inntaket er minst 4 µg (5). Størsteparten av kobalamin finst lagra i levra. Vitaminet blir tilført blodet etter behov, og reduserte serumkonsentrasjonsmål av kobalamin gjenspeglar ikkje alltid vitamin B12-mangel (6). Ein meir spesifikk og indirekte laboratorieanalyse i utgreiing av B12-mangel er serumkonsentrasjon av metylmalonsyre (MMA) og homocystein (7), der metylmalonsyrekonsentrasjonen er den mest spesifikke markøren av desse to.
Det blei tatt kontrollblodprøver både to og fire dagar etter seponering av olanzapin, der retikulocyttar blei målt til 0,03 × 1012/L (0,03–0,11). Øvrige verdiar i blodbildet var også stasjonære. Det var ein nedgang i CRP frå 8 mg/L til under 5 mg/L, med samtidig stigning i ferritin frå 798 µg/L til 966 µg/L. Homocystein i serum blei målt til 6,9 µmol/L (≤ 15). Pasienten var vedvarande symptomfri. Det blei ikkje påvist antistoff mot hepatitt B, hepatitt C, hiv-1, hiv-2, cytomegalovirus, Epstein-Barr-virus eller syfilis. Pasienten hadde positivt utslag for parvovirus B19 IgG, foreinleg med tidlegare gjennomgått infeksjon.
Retikulocyttar er umodne raude blodceller. Mange retikulocyttar betyr som regel stor produksjon av blod. Få retikulocyttar og samtidig anemi gir mistanke om defekt erytropoese. Ved behov kan erytropoesen auke dramatisk, med resulterande stigning i talet på retikulocyttar (8). Ved B12-mangel og elles normal beinmergsfunksjon vil ein derfor forvente relativt rask hematopoetisk respons etter tilførsel av B12.
Grunna mangel på hematopoetisk respons etter fem B12-injeksjonar og seponering av olanzapin blei det på ny konferert med hematolog. Homocysteinnivået var ikkje forhøga, som saman med normal MCV-verdi talte imot B12-mangel som forklaring på cytopenien. Det blei heller ikkje påvist aktuelle infeksjonar som kunne forklare forstyrringane i blodbildet. Seks døgn etter innlegginga blei det utført beinmergsundersøking med biopsi og aspirat til mikroskopi og væskestraumscytometri. Beinmergsaspiratet blei vurdert mikroskopisk same kveld, med funn av massiv infiltrasjon av mellomstore, monotone umodne celler og fortrengt hematopoese (figur 1). Det blei straks konferert med hematologisk bakvakt på universitetssjukehus, og pasienten blei meldt til overflytting med mistanke om akutt leukemi.
Uttalt nøytropeni er ein alvorleg tilstand knytt til høg mortalitet. Nesten éin av ti kreftpasientar lagt inn med febril nøytropeni døyr i forløpet (9). Alvorleg nøytropeni må derfor utgreiast nøye. Pasienten i kasuistikken hadde moderat nøytropeni allereie fem månadar før innlegginga. Lett til moderat isolert nøytropeni hos norske vaksne er sjeldan betinga i beinmergssjukdom (10), og blir ofte berre observert utan utgreiing. Hos vår pasient tilkom det etter kvart svikt i fleire cellelinjer, og det var mangel på hematopoetisk respons etter seponering av aktuelle medikament. Ein bør då mistenke primær beinmergssjukdom.
Væskestraumscytometri av dei kjernehaldige cellene i beinmergen viste ein klonal populasjon på ca. 89 % umodne B-lymfocyttar. Tumorcellene var morfologisk og immunfenotypisk godt foreinleg med akutt lymfoblastisk leukemi (ALL). Supplerande mutasjonsanalysar viste signalmønster svarande til ETV6::RUNX1-genfusjon.
Det blei starta leukemibehandling i tråd med protokollen til Nordisk foreining for pediatrisk hematologi og onkologi (NOPHO). Okskarbazepin blei seponert til fordel for det mindre enzyminduserande medikamentet levetiracetam som epilepsiprofylakse. Denne hadde god effekt på anfallshyppigheita. Væskestraumscytometri av beinmerg på dag 79 viste < 0,0004 % celler med lik fenotype som dei opphavlege leukemicellene, foreinleg med komplett respons av akutt lymfoblastisk leukemi utan målbar residualsjukdom. Den totale behandlingstida er tenkt å gå over 2,5 år, med gode utsikter for kurasjon.
Diskusjon
Vår pasient hadde hatt gjentatte akutte forbigåande psykotiske episodar i etterkant av alkoholinntak. Ved to av episodane var det også skildra epileptiske anfall i intervallet mellom alkoholinntak og debut av psykotiske symptom. Alkoholinntak kan auke risikoen for epileptiske anfall (11). Etiologien bak dei psykotiske episodane til pasienten vår kan vi ikkje fastslå sikkert. Ein kan tenke seg at autismespekterforstyrringa medfører lågare psykoseterskel og at alkoholinntak aleine har vore nok til å utløyse psykose. Samtidig hadde pasienten ein kjent tendens til epileptiske anfall under søvn, og ein kan undre seg på om han kan ha hatt ikkje-erkjente epileptiske anfall i søvne i dei tilfella der det ikkje er skildra epilepsianfall før psykosedebut. Episodane som kom etter epileptiske anfall, kan oppfattast som postiktale psykosar.
Postiktal psykose er den vanlegaste epilepsirelaterte psykoselidinga og oppstår som regel eit par døgn etter ein serie med anfall (12, 13). Symptoma inkluderer vrangførestillingar, hallusinasjonar og unormal affekt, og dei varer sjeldan lenger enn 2–7 døgn (14).
Ved alle epilepsirelaterte psykosar er anfallskontroll hjørnesteinen i behandlinga. Det finst anbefalingar om antipsykotisk behandling, men desse er i hovudsak baserte på klinisk erfaring. Grunnlag i kontrollerte studiar er mangelfullt (12). Pasienten vår brukte ein uvanleg låg profylaktisk døgndose olanzapin, som blei firedobla under innlegging på psykiatrisk akuttavdeling. Dei psykotiske symptoma gjekk i regress på denne dosen, og etter seks dagar blei medikamentet seponert på grunn av alvorleg nøytropeni. Pasienten sin mentale status forblei stabil etter dette, utan bruk av antipsykotika. Effekten av olanzapin på dei psykotiske symptoma er vanskeleg å vurdere sikkert.
Vår pasient hadde ved innlegging på akuttpsykiatrisk avdeling teikn på beinmergssvikt. Vanlege debutsymptom på leukemi, som slappheit, infeksjonstendens, vekttap, blødingstendens og forstørring av lymfeknutar og milt var ikkje til stades. Mistanken om akutt hematologisk sjukdom var derfor låg, også fordi forandringane i blodbildet blei antatt å ha utvikla seg over lengre tid.
Antipsykotikumet olanzapin peikte seg tidleg ut som mogleg årsak til blodprøveavvika. Pasienten hadde brukt medisinen fast dei siste fem månadane og i same periode opplevd betydeleg reduksjon i alle dei tre hematologiske cellelinjene. Likevel kan vi merke oss at pasienten allereie før oppstart av olanzapin hadde moderat reduserte nivå av nøytrofile granulocyttar, som då målte 0,97 × 109/L (1,80–6,90 × 109/L). Øvrige cellelinjer var på dette tidspunktet normale. Lett nøytropeni kjem sjeldan av alvorleg sjukdom og er ofte forbigåande. Sett i ettertid er det sannsynleg at dette funnet var eit tidleg teikn på leukemi.
Akutt lymfoblastisk leukemi er ei sjeldan form for blodkreft med rundt 70 nyoppdaga årlege tilfelle (15, 16). Akutt lymfoblastisk leukemi er den vanlegaste kreftforma hos barn, og dei fleste som får sjukdomen er under 18 år. I 2023 blei det registrert 33 tilfelle av akutt lymfoblastisk leukemi hos vaksne (15, 16).
Sjukdomen blir vanlegvis mistenkt gjennom kombinasjonen av unormale blodverdiar og varsel frå celleteljaren om avvikande kvite blodceller. I nokre tilfelle av akutt lymfoblastisk leukemi slepp ikkje blastane ut gjennom blod-beinmerg-barrieren, og diagnosen kan berre stillast gjennom beinmergsprøve. Hos pasienten vår var det nokre få prosent blastar i blod, og sett i ettertid kunne nok diagnosen blitt stilt tidlegare viss ein hadde mikroskopert eit blodutstryk.
Beinmergsundersøkinga av vår pasient var morfologisk godt foreinleg med akutt lymfoblastisk leukemi, og væskestraumscytometri av tumorcellene sikra diagnosen. Supplerande kromosomanalysar avdekka genfusjonen ETV6::RUNX1. Fusjonen inntreffer i fosterlivet og oppstår som eit resultat av translokasjonen t(12;21). Avviket er den hyppigaste varianten av akutt lymfoblastisk leukemi hos barn, men er svært sjeldan hos vaksne (17). Genfusjonen gir ikkje kreft i seg sjølv og er avhengig av samspel med andre genmutasjonar for å gi leukemi. Avviket er relativt vanleg hos friske nyfødde (18).
Vår pasient er etter alt å døme fødd med genfusjonen ETV6::RUNX1, men utvikla ikkje leukemi før i vaksen alder. Ved diagnosetidspunktet var pasienten heilt utan kliniske teikn på alvorleg hematologisk sjukdom. Vi stiller oss spørsmål om kvifor pasienten utvikla ein leukemi nesten utelukkande sett hos barn, og om korleis pasienten kunne framstå klinisk frisk med ein samtidig betydeleg underliggande tumorbyrde. Kan pasienten ha blitt utsett for andre karsinogene risikofaktorar? Kan pasienten ha hatt leukemiceller ulmande over lang tid?
For meg som pasient, og for pårørande, var det viktig at diagnosen vart oppdaga tidleg og tatt raskt på alvor.
Det har vore trygt å få all oppfølging og behandling på universitetssjukehuset. Både for meg og pårørande. Viktig for å finne roa, bli kjent med legar og anna personell og rutinar. Det har vore til hjelp for korleis det er å takle sjukdomen og den lange behandlinga.
Samspelet mellom kreft og epilepsi er omdiskutert. Sentrale spørsmål i debatten er relativ insidens av kreftsjukdom hos pasientar med epilepsi og om antiepileptika speler ei rolle i tumorutvikling og -suppresjon. Ei rekke antiepileptika er vist karsinogene i dyreforsøk, men det føreligg i dag ingen klare samanhengar mellom kreftutvikling og antiepileptika hos menneske (19). Samtidig er dei hematologiske biverknadane av antiepileptika veletablert. Utvikling av akutt lymfoblastisk leukemi hos pasientar med langtidsbruk av karbamazepin, nært beslekta med okskarbazepin, som vår pasient brukte, er skildra i fleire kasuistikkar, men samanhengen er uklar (20, 21).
Tilgjengeleg forsking lar oss ikkje forklare med sikkerheit årsakssamanhengen bak sjukdomen til pasienten vår. Om antiepileptika er ein risikofaktor for leukemi i møte med ugunstige medfødde genetiske avvik, er usikkert. Effektane av langtidseksponering av antiepileptika synest på grunnlag av kasuistikken å vere ein god kandidat for vidare forsking.
Hos vår pasient utpeikte legemiddelbiverknadar seg tidleg ut som potensiell årsak til blodprøveavvika. Kasuistikken illustrerer viktigheita av grundig somatisk utgreiing også ved psykiske symptom. Kjente årsaker til hematologiske avvik bør ikkje utelukke primær hematologisk liding. Ved vedvarande cytopeniar utan klar årsak bør ein tidleg konferere med indremedisinar eller hematolog.
Pasienten har samtykt til at artikkelen blir publisert.
Artikkelen er fagfellevurdert.
- 1.
Chisholm K, Lin A, Abu-Akel A et al. The association between autism and schizophrenia spectrum disorders: A review of eight alternate models of co-occurrence. Neurosci Biobehav Rev 2015; 55: 173–83. [PubMed][CrossRef]
- 2.
Clancy MJ, Clarke MC, Connor DJ et al. The prevalence of psychosis in epilepsy; a systematic review and meta-analysis. BMC Psychiatry 2014; 14: 75. [PubMed][CrossRef]
- 3.
Torp HA, Nystøyl B. Nøytropeni ved behandling med antipsykotika. Tidsskr Nor Legeforen 2020; 140. doi: 10.4045/tidsskr.19.0713. [PubMed][CrossRef]
- 4.
Felleskatalogen. Olanzapin tab 2,5 mg. https://www.felleskatalogen.no/medisin/internsok?type=fktekst-liste&felt=sctid&sokord=321618003 Lese 8.5.2025.
- 5.
Bjørke-Monsen AL. Utredning av kobalaminstatus. Tidsskr Nor Legeforen 2020; 140. doi: 10.4045/tidsskr.19.0589. [PubMed][CrossRef]
- 6.
Wickramasinghe SN. Diagnosis of megaloblastic anaemias. Blood Rev 2006; 20: 299–318. [PubMed][CrossRef]
- 7.
Lande B, Svihus B. Kobalamin. https://sml.snl.no/kobalamin Lese 6.1.2025.
- 8.
Waage A. Retikulocytter. https://sml.snl.no/retikulocytter Lese 13.2.2025.
- 9.
Kuderer NM, Dale DC, Crawford J et al. Mortality, morbidity, and cost associated with febrile neutropenia in adult cancer patients. Cancer 2006; 106: 2258–66. [PubMed][CrossRef]
- 10.
Tjønnfjord SKV, Ali MM, Tjønnfjord GE. Kronisk nøytropeni hos voksne. Tidsskr Nor Legeforen 2023; 143. doi: 10.4045/tidsskr.22.0491. [PubMed][CrossRef]
- 11.
Bråthen G. Alkohol og epilepsi. Tidsskr Nor Lægeforen 2003; 123: 1536–8. [PubMed]
- 12.
Henning O, Nakken KO. Epilepsirelaterte psykoser. Tidsskr Nor Legeforen 2013; 133: 1205–9. [PubMed][CrossRef]
- 13.
Stern T, Fava M, Wilens T et al. Massachusetts General Hospital Comprehensive Clinical Psychiatry. 3. utg. Amsterdam: Elsevier, 2024: 867.
- 14.
Trimble M, Kanner A, Schmitz B. Postictal psychosis. Epilepsy Behav 2010; 19: 159–61. [PubMed][CrossRef]
- 15.
Kreftregisteret. Årsrapport 2023. Nasjonalt kvalitetsregister for lymfoide maligniteter. https://www.fhi.no/globalassets/publikasjoner-og-rapporter/arsrapporter/publisert-2024/arsrapport-2023-nasjonalt-kvalitetsregister-for-lymfoide-maligniteter.pdf Lese 27.5.2025.
- 16.
Quist-Paulsen P. Akutt lymfatisk leukemi. https://sml.snl.no/akutt_lymfatisk_leukemi_-_ALL Lese 13.2.2025.
- 17.
Harrison CJ. Targeting signaling pathways in acute lymphoblastic leukemia: new insights. Hematology Am Soc Hematol Educ Program 2013; 2013: 118–25. [PubMed][CrossRef]
- 18.
Lausten-Thomsen U, Madsen HO, Vestergaard TR et al. Prevalence of t(12;21)[ETV6-RUNX1]-positive cells in healthy neonates. Blood 2011; 117: 186–9. [PubMed][CrossRef]
- 19.
Singh G, Driever PH, Sander JW. Cancer risk in people with epilepsy: the role of antiepileptic drugs. Brain 2005; 128: 7–17. [PubMed][CrossRef]
- 20.
Goyal C, Bhandari V, Rafi M. Long term carbamazepine therapy induced acute lymphoblastic leukemia. Int J Basic Clin Pharmacol 2013; 2: 222–3.
- 21.
Sayin S, Bagci M. Acute lymphocytic leukemia in a patient with long-term carbamazepine exposure: Acute lymphoblastic leukemia that develops in a patient who has been using carbamazepine for a long time. J Oncol Pharm Pract 2023; 29: 477–8. [PubMed][CrossRef]